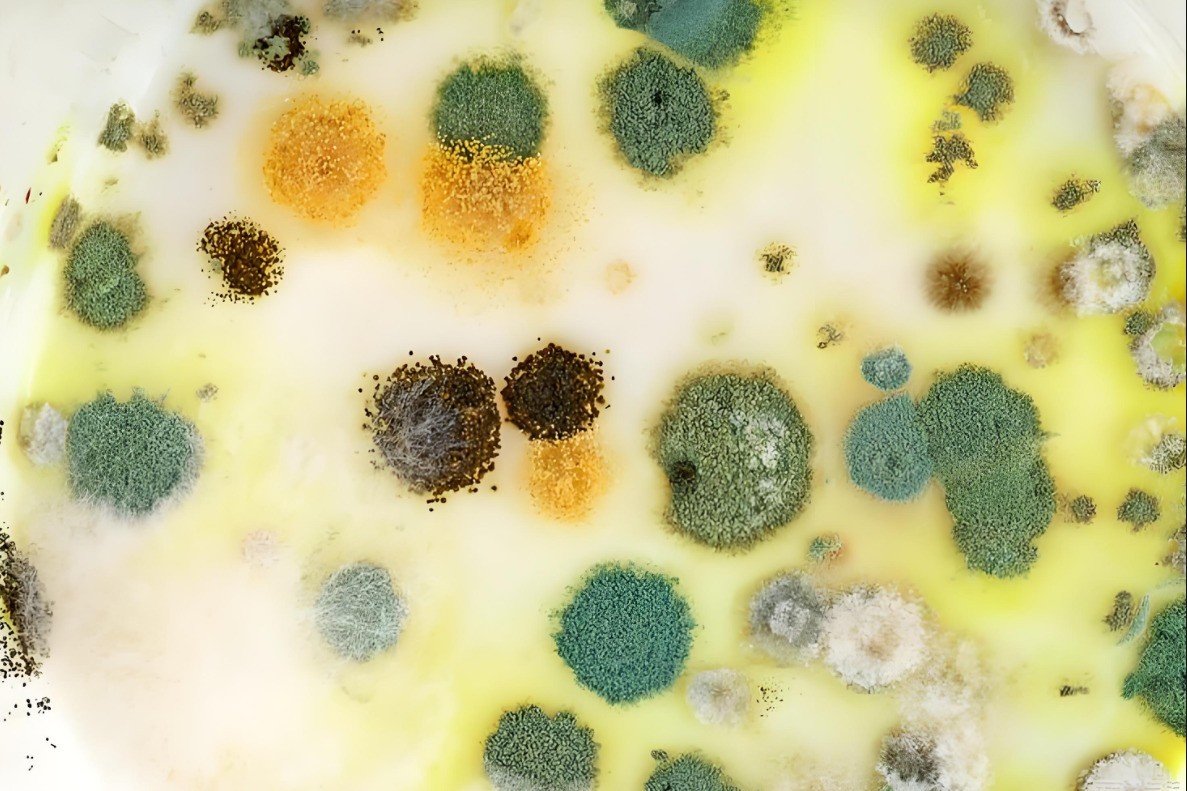

夏天,一定要小心 “冰箱杀手” 李斯特菌
【ZOL中关村在线原创技巧应用】在骄阳似火的夏天,冰箱成了人们保存食物的 “避风港”,很多人认为,只要把食物放进冰箱,就能高枕无忧。殊不知,一种名为李斯特菌的 “隐形杀手”,正借着冰箱的低温环境悄然生长、伺机而动。在这个夏天,我们必须深入了解它、警惕它,才能守护好自己和家人的健康。
低温 “宠儿”:独特生存特性的李斯特菌
大多数细菌在低温环境下生长繁殖会受到抑制,甚至死亡,但李斯特菌却与众不同,堪称细菌界的 “耐寒勇士”。它是一种嗜冷菌,能够在 0 - 45℃的宽泛温度区间内生长,尤其在 2 - 4℃这个冰箱冷藏室的常见温度范围内,它能悠然自得地繁衍,即使被置于零下 20℃的冷冻室,李斯特菌也不会轻易 “缴械投降”,而是进入休眠状态,蛰伏长达一年之久 。
这种独特的生存特性,打破了人们对冰箱杀菌保鲜的固有认知,冰箱不再是隔绝细菌的 “保险箱”,反而成为了李斯特菌的 “温床”,当人们从冰箱中取出看似新鲜的食物时,可能已经与李斯特菌 “亲密接触” 而不自知。
无声威胁:李斯特菌的健康危害
李斯特菌感染对不同人群的影响差异巨大,对于免疫力正常的成年人而言,感染后症状通常较为轻微,一般表现为发热、腹泻、肌肉酸痛等类似流感的症状,这些症状往往会在 1 - 2 天内自行缓解,因此容易被忽视。
然而,对于孕妇、婴幼儿、老年人以及免疫力低下人群来说,李斯特菌却是不折不扣的 “健康大敌”。孕妇一旦感染李斯特菌,病菌会通过胎盘传递给胎儿,极易导致早产、流产、等悲剧发生;即便胎儿顺利出生,也可能患上败血症、脑膜炎等严重疾病,给孩子的一生带来沉重负担。老年人和免疫力低下者感染后,由于身体抵抗力弱,更容易引发脑膜炎、败血症等重症。据世界卫生组织数据显示,全球每年约有 3000 人因李斯特菌感染死亡,病死率高达 20% - 30%,其危害程度令人触目惊心。
无孔不入:李斯特菌的传播路径
李斯特菌的传播途径复杂多样,在食物生产的源头就已经埋下了隐患,它能够污染土壤、水源,进而感染农作物、禽畜和水产品。例如,生菜、豆芽等绿叶蔬菜在生长过程中,如果接触到被污染的水源或土壤,就很容易携带李斯特菌;未经严格杀菌处理的牛奶、奶酪等乳制品,以及未完全煮熟的肉类、蛋类,也常常成为李斯特菌的藏身之所。
进入家庭后,冰箱内的交叉污染更是李斯特菌传播的重要途径,生肉、生鱼等食材表面携带的李斯特菌,会通过接触、飞溅等方式污染其他食物。若冰箱内食物摆放混乱,没有做到生熟分开,或者冰箱长期不清洁,内部积累大量细菌,李斯特菌就会趁机大肆传播,让整个冰箱都成为它的 “传播基地”。
科学防范:抵御李斯特菌的有效策略
要防范李斯特菌的侵害,我们需要从多个方面入手,养成科学的生活习惯。在食物采购环节,应优先选择新鲜食材,仔细检查食品包装是否完好,避免购买临近保质期的食品;尽量选择经过巴氏杀菌的乳制品,从源头上降低感染风险。

冰箱内的食物摆放大有讲究,遵循生熟分开原则,将生肉、生鱼等食材密封包装后放置在冰箱下层,防止血水渗漏污染其他食物;蔬菜水果洗净沥干后,用保鲜袋或保鲜盒分装存放,避免与其他食物交叉污染。同时,严格控制食物在冰箱内的储存时间,熟食存放不宜超过 3 天,冷冻食品解冻后应尽快食用,切勿反复冷冻;剩饭剩菜再次食用前,务必彻底加热至 70℃以上,并持续加热数分钟,确保杀死李斯特菌。
定期清洁冰箱是预防李斯特菌滋生的关键,建议每周至少对冰箱进行一次内部清洁,用稀释后的白醋或专用清洁剂擦拭冰箱内壁、搁板和抽屉,清除细菌和污渍;每月进行一次深度清洁,断电后取出所有食物,全面清理冰箱内部,必要时可使用含氯消毒剂进行消毒。
写在最后:
夏天,冰箱给我们带来了清凉与便利,但 “冰箱杀手” 李斯特菌也隐藏其中。我们不能因为冰箱的存在就放松警惕,而应将科学的防范措施融入日常生活,增强防范意识,多方共同努力,才能在享受夏日美食的同时,守护好自己和家人的健康。